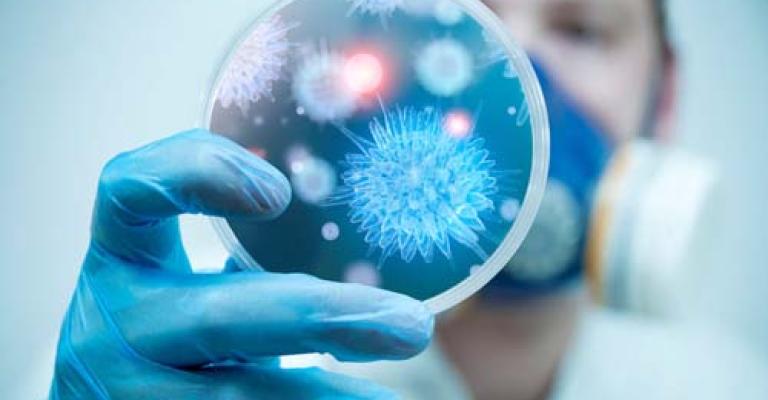
"الصحة" تجدد تحذيراتها للمواطنين المتجهين للحج لتجنب الإصابة بـ "الكورونا"

- شبكة الإعلام المجتمعي، التي تضم راديو البلد 92.5 FM وموقع عمان نت، تعقد مؤتمرها الإقليمي الثاني بعنوان: "إعلام مستقل… مجتمع قوي"، وذلك يومي الاثنين والثلاثاء
- توقيع أول اتفاقية استثمار لإنتاج الأمونيا الخضراء في الأردن، بتكلفة مليار دولار، بين وزارة الطاقة والثروة المعدنية وشركة الأردن للأمونيا الخضراء
- المؤسسة العامة للضمان الاجتماعي تعلن الأحد أن مقدار الزيادة السنوية على رواتب متقاعدي الضمان للعام الحالي 2026 بلغ ستة دنانير وسبعون قرشا
- رئيس قسم الشؤون القانونية في إدارة ترخيص السواقين والمركبات، المقدم نادر حجازين، يؤكد بدء تطبيق التعليمات المعدلة للفحص الفني صباح الأحد
- مديرية أشغال محافظة الزرقاء،تبدأ بتنفيذ حملة ميدانية واسعة لإزالة الأكشاك المخالفة والمعتدية على حرم الطريق العام على طريق أوتوستراد الزرقاء – المفرق
- وزارة الصحة الفلسطينية في قطاع غزة، تقول الأحد، إن إجمالي من وصلوا إلى مستشفيات القطاع خلال الـ24 ساعة الماضية بلغ شهيدا واحدا، فيما بلغ عدد الإصابات 4.
- هيئة عمليات التجارة البحرية البريطانية، تقول الأحد، أن ناقلة "بضائع سائبة" أبلغت عن تعرضها للاستهداف بمقذوف مجهول خلال إبحارها قبالة سواحل قطر
- يطرأ الأحد، ارتفاع على درجات الحرارة لتسجل أعلى من معدلاتها المناخية لمثل هذا الوقت من السنة بحوالي 5-6 درجات مئوية ويبقى الطقس دافئا في أغلب المناطق
عمان نت

احتل الأردن المرتبة 64 عالميا و 9 عربيا على قائمة الجيوش الأقوى في العالم. ونشر موقع "غلوبال فاير باور" ترتيبًا لأقوى جيش في العالم منتصف آب الجاري، حيث تربع فيه الجيش الأمريكي على موقع الصدارة
ألغى مجلس العمداء في جامعة جدارا منح طالب شهادة البكالوريوس، بعد حادثة "بصقه على أكاديمين في منصة الترخيج هذا الأسبوع. وقال رئس الجامعة الدكتور صالح العقيلي لـ عمّان نت أن الجامعة نسبّت لوزارة التعليم

أكد رئيس هيئة مستثمري المناطق الحرة الأردنية نبيل أبو رمان، أن قرار مجلس الوزراء القاضي بإعفاء بطاريات المركبات الهجينة "الهايبرد" من ضريبة المبيعات، سينعكس إيجابيا على التجار، والتقليل من أعبائهم

قالت أمانة عمّان أنها طرحت عطاء خلطة اسفلتية بقيمة 2 مليون و400 ألف دينار تغطي مساحة 430 ألف متر مربع، بالإضافة إلى عطاء مصنعية بقيمة 200 ألف دينار و يغطي 400 الف متر مربع، لصيانة الشوارع. ووفقا لمدير

قال مصدر حكومي أردني اليوم الأربعاء لـ عمّان نت أن أي مراقب موضوعي للشأن السوري يرى من الذي يأتمر لإيران وروسيا بل وحزب الله، في ردٍ على اتهام الرئيس السوري بشار الأسد للأردن بعدم الاستقلالية. ووجه
جددت وزارة الصحة تحذيراتها للمواطنين المتجهين لأداء مناسك الحج قبيل عيد الأضحى بأخذ الحيطة والحذر واتباع الإرشادات الصحية لتجنب إصابتهم بمرض الكورونا المنتشر في الدولة السعودية. وشدد مدير إدارة

دان الأردن اليوم الأربعاء إغلاق سلطات الاحتلال الإسرائيلي عددا من أبواب المسجد الأقصى/ الحرم القدسي في وجه المصلين المسلمين والسماح باقتحام المتطرفين والمستوطنين للمسجد الأقصى/ الحرم القدسي تحت حماية

تضاربت الأنباء حول تغيير اسم مدرسة في قطاع غزة من"غسان كنفاني" إلى "مرمرة"، الأمر الذي أثار موجات استنكار من جهة ومن جهة أخرى دعوات للتدقيق في تفاصيل الخبر الذي بدأت تتناقله وسائل إعلام منذ مساء أمس

أصيب 8 أشخاص بجروح ورضوض مختلفة في الجسم إثر حادث تصادم وقع بين مركبتين على جسر الزهور/ باتجاه ضاحية الياسمين في العاصمة عمّان حيث قامت فرق الإسعاف في مديرية دفاع مدني شرق عمان بتقديم الإسعافات

أخلت كوادر دفاع مدني إربد بالتعاون مع شرطة إربد فجر اليوم الأربعاء 17 طفلا حديثي الولادة بينهم طفلا خداج من المستشفى الإسلامي إلى مستشفى الأمير راشد العسكري إثر اندلاع حريق محدود نجم عن عطل في أحد












































